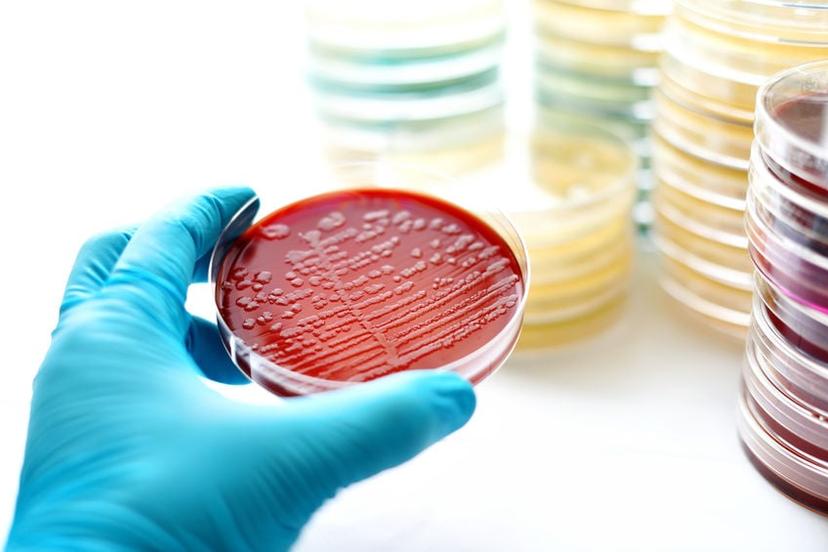
Total Process Control - Sepsis

8 upcoming webinars to boost your research
Discover the latest tools and techniques to expand your research capacity with expert-led presentations on molecular controls, cell line development, natriuretic peptides, stem cells, and more
22 Sept 2022
Expert insights

SelectScience® hosts dozens of informative free webinars for scientists every month, featuring world-class speakers at the very forefront of their respective fields. In this regular feature, we highlight the events you won't want to miss over the next week or so, as well as some of our top on-demand webinars.
This week, discover the value of molecular controls, explore the crucial role of stem cell transplantation in the treatment of blood malignancies, learn about the benefits of early integration of ultrapure water supplies throughout a building, and find out how to simplify your cell line development workflow.
Plus, gain insight into comprehensive vehicle emissions testing using thermal desorption, review the use of natriuretic peptide testing in clinical practice, discover the importance of partnerships in conducting large scale cancer screening studies, and learn more about sepsis diagnosis, management, and treatment.
The value of molecular controls for validation and routine monitoring in an accredited lab

Join Lora Bean, Senior Director of Quality Assurance at PerkinElmer Genomics, as she shares the best practices for labs currently using and looking to implement accreditation with proficiency schemes including College of American Pathologists (CAP) and International Organisation for Standardisation (ISO).
Monday, September 26, at 16:00 BST / 17:00 CEST / 11:00 EDT / 08:00 PDT
Genome-wide association study on 13,167 individuals identifies regulators of blood CD34+ cell levels

Stem cell transplantation is crucial in the treatment of blood malignancies and requires the mobilization of CD34+ hematopoitic stem cells. Björn Nilsson, Professor of Clinical Immunology at Lund University, Sweden, will present his research using the high throughput capabilities of Bio-Rad’s ZE5™ Cell Analyzer, together with genome-wide association studies (GWAS) to better understand the genetic architecture of blood CD34+ cell levels as a means to identify potential targets for stem cell mobilization.
Monday, September 26, at 16:00 BST / 17:00 CEST / 11:00 EDT / 08:00 PDT
How to seamlessly integrate the supply of purified water in new laboratory construction

Pure water supply plays a critical role in today’s laboratories. In this expert webinar, learn about the benefits of early integration of the pure and ultrapure water supply throughout a building. Plus, discover the benefits of other water purification system features, including ergonomic design, data management, and digital solutions, with a lower environmental impact, will be highlighted.
Tuesday, September 27, at 15:00 BST / 16:00 CEST / 10:00 EDT / 07:00 PDT
Tools to streamline cell line development for biotherapeutics

Successful cell line development (CLD) is heavily dependent upon balancing time and resources with acquiring high-quality data for informed decisions. This webinar focuses on early-stage cell line development with instrumentation that is tailored for high-throughput screening, enabling reliable identification of robust, scalable, and high-titer clones.
Tuesday, September 27, at 16:00 BST / 17:00 CEST / 11:00 EDT / 08:00 PDT
Comprehensive vehicle emissions testing using thermal desorption (TD) and GC×GC–TOF MS

With the increased uptake of hybrid and electric vehicles, non-exhaust emissions are now of growing environmental concern. In this webinar, our guest speaker, Dr Nick Molden, (Emissions Analytics), will demonstrate the use of thermal desorption (TD) for versatile sampling of emissions from exhausts, vehicle interiors and tyres.
Wednesday, September 28, at 16:00 BST / 17:00 CEST / 11:00 EDT / 08:00 PDT
Natriuretic peptides and heart failure: Clinical practice application now and in the future

The use of natriuretic peptide testing in clinical practice provides information that may not be obvious at the patient’s bedside. This online seminar discusses the latest clinical application of natriuretic peptides, examining how testing may support clinical judgment, reduce cost, and decrease serious medical events.
Wednesday, September 28, at 16:00 BST / 17:00 CEST / 11:00 EDT / 08:00 PDT
The importance of gold standard partnerships in conducting large scale cancer screening studies

In this webinar, Mike Sheldon, Director of Scientific Affairs at Sampled and Erika Vento-Gaudens, Director of Global Clinical Studies Operations at Guardant, will describe the partnership established between Guardant Health and Sampled to build a study workflow that spans from subject enrollment through sample collection, processing, distribution, and analysis.
Thursday, September 29, at 16:00 BST / 17:00 CEST / 11:00 EDT / 08:00 PDT
Total Process Control - Sepsis
Up to 49 million people are affected by sepsis worldwide. In this webinar, join Dr. Tobin Efferen and Hunter Bowen from Beckman Coulter Diagnostics, as they discuss sepsis diagnosis and management and highlight the use of standardized laboratory and clinical operations in the context of one patient’s journey, from initial assessment in the Emergency Department to treatment in the ICU and eventual discharge.
Friday, September 30, at 15:00 BST / 16:00 CEST / 10:00 EDT / 07:00 PDT
Watch our webinars at a time that suits you
Missed one of our webinars? Fortunately, all SelectScience webinars are made available on demand after the live event. Catch up on some of our latest webinars below:
3rd HPTLC Online User Meeting, hosted by the HPTLC Association
Two-dimensional liquid chromatography (2D-LC): A tutorial focusing on best practice
Lowering the energy barrier to great chemistry with ChemDraw & ChemOffice
Gaining insights into DNA damage response (DDR) in cancer cells with image-based quantificatio
High-sensitivity point-of-care cardiac troponin: Novel whole-blood testing at last
What can biological EDS do for you? The answers to frequently asked questions on analytical biological electron microscopy
Focus on the key players: Surveying the proteome with high-density antibody panels
An alternative approach using GC-Orbitrap MS for the analysis of pesticide residues in food
SelectScience runs 10+ webinars a month across various scientific topics, discover more of our upcoming webinars>>
